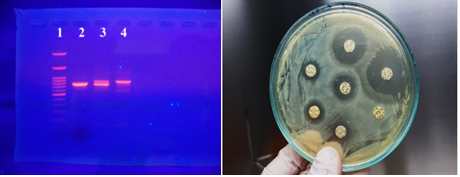

TRUNG TÂM CHẨN ĐOÁN - XÉT NGHIỆM THÚ Y THEO TIÊU CHUẨN ISO 17025:2017
Phòng Chẩn đoán - Xét nghiệm Thú y là bộ phận thuộc Trung tâm nghiên cứu và phát triển Công nghệ vác xin, công ty Cổ phần Avac Việt Nam.
Thành lập từ năm 2012, trung tâm được trang bị thiết bị, máy móc hiện đại, đội ngũ kỹ thuật viên trẻ, chuyên nghiệp. Trung tâm được điều hành bởi TS. Nguyễn Văn Điệp, người có hơn 8 năm kinh nghiệm nghiên cứu tiến sĩ và sau tiến sĩ về bệnh lý và virus học thú y tại Nhật Bản.
Trung tâm đạt chứng chỉ ISO/IEC 17025:2017 trong lĩnh vực sinh học, được công nhận là phòng thử nghiệm ngành nông nhiệp và phát triển nông thôn mã số LAS-NN 23 theo quyết định số 386/QĐ-TY-KH ngày 11/07/2017
.jpg)
Trung tâm được đầu tư trang thiết bị hiện đại, hệ thống máy móc hiện đại: Máy PCR; Máy Realtime PCR; Máy ELISA; Máy ly tâm; Tủ an toàn sinh học cấp II; Tủ ủ tế bào, virus, vi khuẩn, …và được quản lý, vận hành bởi đội ngũ Tiến sĩ, Thạc sĩ, Bác sỹ thú y tốt nghiệp tại các Trường Đại học trong và ngoài nước

Năng lực chẩn đoán xét nghiệm
- Phát hiện sự có mặt của vi sinh vật gây bệnh.
- Phát hiện và định lượng kháng thể kháng virus hoặc vi khuẩn trong huyết thanh gia súc, gia cầm do nhiễm vi sinh vật tự nhiên hoặc do sử dụng vắc xin phòng bệnh.
- Kháng sinh đồ, xét nghiệm chất lượng nước.
- Phân Lập Virus, Vi khuẩn.
Trung tâm cam kết:
- Kết quả nhanh, chính xác, đúng thời hạn.
- Thông tin khách hàng được bảo mật.
- Hỗ trợ tư vấn cho khách hàng giải pháp phòng và trị bệnh sau khi có kết quả xét nghiệm.
Với phương châm hoạt động TRUNG THỰC – CHÍNH XÁC – KỊP THỜI, chúng tôi cam kết mang sự hài lòng đến quý khách.



Bảng giá có hiệu lực kể từ ngày 01 tháng 01 năm 2021 cho đến khi có báo giá mới. Chúng tôi xin chân thành cảm ơn sự tin tưởng hợp tác của Quý vị!
Ghi chú:
- Cùng một mẫu, xét nghiệm chỉ tiêu thứ hai cùng 1 phương pháp (PCR hoặc RT-PCR) thì chỉ tiêu thứ 2 giảm 50%.
- Hiện tại đối với mẫu bệnh viêm khớp do virus Reovirus mẫu dương tính sẽ được giảm 50%.
- Thời gian nhận mẫu bệnh phẩm: Từ 8h sáng - 17h chiều cùng ngày (Từ thứ 2 đến thứ 7 hàng tuần).
- Mẫu bệnh phẩm vận chuyển về phòng thí nghiệm cần được bảo quản trong điều kiện lạnh 2 - 8˚C (có thể bảo quản mẫu bệnh phẩm trong hộp xốp có đá lạnh).
- Giá trên đã bao gồm thuế VAT.
Các chỉ tiêu xét nghiệm khác không có trong danh mục này sẽ tính theo chỉ tiêu tương đương.
Nguyễn Văn Đức - Phone: 033.861.3990
Công ty Cổ phần AVAC VIỆT NAM
- Lĩnh vực kinh doanh
- Sản phẩm cho lợn
- Sản phẩm cho gia cầm
- Sản phẩm cho gia súc
- Sản phẩm nhập khẩu
- Dịch vụ chẩn đoán xét nghiệm
- Giới thiệu công ty

Công ty Cổ Phần AVAC Việt Nam với định hướng: Con người hạng A – Hệ thống hạng A – Chất lượng hạng A nhằm nghiên cứu, sản xuất, cung ứng các sản phẩm vaccine cho ngành chăn nuôi Việt Nam và hướng tới xuất khẩu.
- Xem thêm


